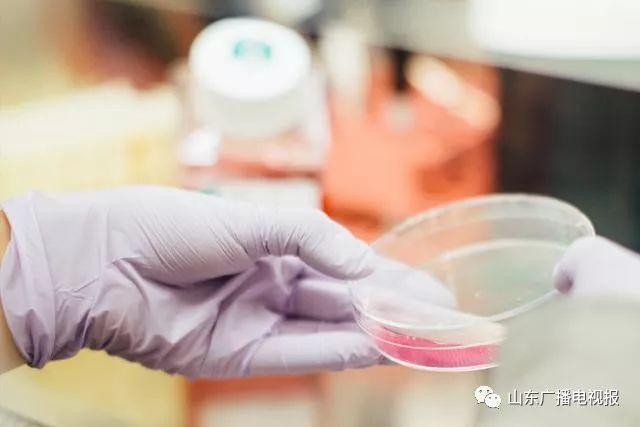
科普生活app:你的随身科学顾问,让知识获取像呼吸一样简单 科普生活app:你的随身科学顾问,让知识获取像呼吸一样简单

打开科普生活app的瞬间,你可能会被它清爽的界面吸引。蓝色与白色交织的配色方案,像翻开一本科学杂志的扉页。图标设计采用扁平化风格,每个功能入口都配有简洁的图标和文字说明。这种视觉设计不仅美观,更重要的是让用户能够快速理解每个区域的功能定位。
核心功能:你的随身科学顾问
首页顶部的搜索栏支持关键词和语音搜索。输入“极光形成原理”,三秒内就能获取图文并茂的解析。我上个月准备给孩子讲解这个现象时,就是靠这个功能找到了适合不同年龄段的解释版本。
内容分类采用智能标签系统。物理学、生物学、天文学等主要学科都有独立入口,每个学科下又细分了基础概念、前沿研究、生活应用等子类别。这种层级结构让知识获取变得像在图书馆按索引找书一样方便。
每日推送功能会根据你的浏览记录和收藏内容,推荐相关领域的科普文章。系统算法在不断优化,我注意到最近它开始识别我的阅读偏好——比起纯理论,我更关注科学原理的实际应用。
知识图谱是另一个亮点。查看“量子力学”词条时,页面会显示与之相关的“薛定谔的猫”、“波粒二象性”等概念链接。这种关联式学习帮助用户构建完整的知识体系,而不是获取零散信息。
特色功能:让科学触手可及
AR实验功能把手机变成移动实验室。对准桌面点击“虚拟化学实验”,屏幕立即显示烧杯、试剂等器材。拖动不同试剂混合,app会模拟真实的化学反应过程。这个功能特别适合学生群体,在安全环境下体验实验的乐趣。
科学日历记录着科技史上的重要事件。今天是3月14日,页面会突出显示爱因斯坦诞辰纪念日,并附上相对论的简易解析。这种设计让科学知识带着时间温度,不再冰冷抽象。
社区问答板块聚集了各领域的专业人士。上周有用户询问“为什么微波炉加热食物会不均匀”,半小时内就收到了物理学博士和家电工程师的双重解答。这种跨界交流产生的知识碰撞非常珍贵。
离线下载功能对我这种经常通勤的人特别实用。在地铁信号盲区也能继续阅读已下载内容。实测显示,下载十篇带图片的文章仅占用约50MB存储空间。
对比优势:为何它值得留在你的手机里
与传统科普书籍相比,这个app的内容更新速度是最大优势。新发表的科学研究成果通常在两周内就能转化为通俗易懂的科普内容。而纸质书籍的修订周期往往以年计算。
相较于其他科普应用,它的内容深度梯度设置更为合理。同一个主题会提供“五分钟了解”、“深度解析”、“专业视角”三种版本,满足不同用户群体的需求。这种设计既照顾了普通大众,也不让专业人士觉得内容过于浅显。
知识准确度经过严格把控。每篇文章末尾都标注了审核专家信息和参考文献来源。这种透明化处理增强了内容的可信度,在谣言四起的网络环境中显得尤为可贵。
用户体验的连贯性值得称赞。从内容获取到知识内化形成完整闭环。阅读文章时可以直接标记难点,系统会推荐相关基础概念;完成知识测试后,错题自动归入复习计划。这种设计真正理解了学习者的需求。

我记得第一次使用这个app是为了查证一个朋友圈流传的“科学谣言”。现在它已经成为我手机里使用频率最高的应用之一。在信息过载的时代,能找到一个既专业又易用的知识平台确实不容易。
第一次打开科普生活app时,你可能会好奇如何充分利用这个知识宝库。让我带你一步步探索它的使用方法,就像当初朋友教我时那样亲切自然。
下载安装与注册登录
在应用商店搜索“科普生活”时,你会注意到蓝色星球图标的那个应用。下载包体大约85MB,比很多社交软件都要小巧。安装过程很顺畅,我用的安卓手机大概花了二十秒就完成了。
注册环节提供多种选择。你可以用手机号快速注册,也能通过微信、QQ等第三方账号一键登录。建议绑定手机号,这样换设备时不会丢失学习记录。设置密码时系统会提示强度,但不会强制要求特殊字符——这种人性化设计让我印象深刻。
完成注册后有个简单的兴趣标签选择。勾选你关注的科学领域,这会影响首页的内容推荐。不必担心选错,后期随时可以调整。我记得当时勾选了天文学和生物学,后来发现对材料科学也产生了兴趣,在设置里修改起来非常方便。
登录后的引导界面会展示几个核心功能的快捷入口。花两分钟浏览这些提示,能帮你更快上手。如果跳过引导也没关系,任何时候都能在“我的”页面找到使用指南。
主要功能操作指南
搜索功能的使用比想象中更灵活。除了直接输入关键词,长按搜索图标会启动语音输入。说“黑洞的最新研究”,系统会自动识别并展示相关结果。搜索结果页面左侧有筛选栏,可以按内容类型、难度等级细化查找。
收藏和笔记功能需要稍加练习。阅读文章时点击右下角的星形图标即可收藏。想添加笔记就长按选中文字,会弹出笔记框。这些笔记会自动关联到原文位置,复习时特别方便。我习惯用不同颜色的标签分类笔记,红色标疑问点,绿色标重点概念。
知识测试功能藏在每个知识点的底部。完成阅读后做几道测试题,系统会根据正确率推荐后续学习路径。错题会自动归入“我的错题本”,每周会提醒你复习。这个设计很贴心,像有个私人学习助理。
社区互动操作需要留意几个细节。提问时最好先搜索是否已有类似问题,避免重复。回答他人问题可以获得积分,这些积分能兑换专属课程。点赞和关注功能让优质内容更容易被看见,形成了良好的知识分享氛围。
使用技巧与注意事项
屏幕底部的工具栏其实支持自定义长按。长按“首页”按钮三秒,会弹出常用功能的快捷菜单。这个隐藏功能很多用户都没发现,却能节省大量操作时间。
内容下载建议在WiFi环境下进行。选择下载时,系统会询问要标准画质还是高清画质。除非你需要大量细节图,否则标准画质已经足够清晰,还能节省存储空间。我通常会在通勤前下载五六篇文章,刚好够往返路程阅读。
推送通知管理值得精心设置。在“设置-通知管理”里,你可以选择只接收关注领域的最新研究推送,或者只接收已收藏主题的更新提醒。关闭非必要推送能减少干扰,让学习更专注。
数据同步功能对多设备用户很重要。在“我的-云同步”开启自动同步,这样在平板和手机上的学习进度会实时更新。有次我手机没电了,回家用平板继续阅读,发现所有标记和笔记都完整保留着。
使用过程中有个小细节需要注意。如果长时间停留在某个页面,系统会提示是否开启护眼模式。这个功能确实能减轻视觉疲劳,特别是晚上阅读时。偶尔会遇到内容加载缓慢的情况,通常是网络问题,刷新一下就好。
记得刚开始用时,我总想一次性探索所有功能。后来发现每天花十五分钟专注使用一两个功能,学习效果反而更好。科学知识的积累本来就需要循序渐进,这个app的设计正好契合了这种学习规律。